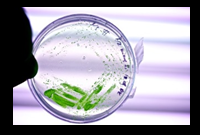

Forschung
Die Forschung der Arbeitsgruppe von Prof. Dr. S. Reumann konzentriert sich auf funktionale und mechanistische Untersuchungen zur Rolle pflanzlicher Peroxisomen in der Pathogenabwehr, in abiotischer Stressresistenz und über die Biogenese von Peroxisomen und deren geregelten Abbau.